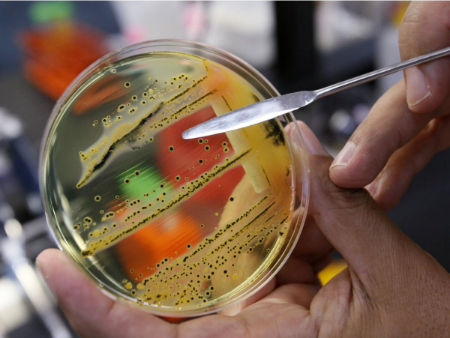

آشنایی با انواع باکتریهای خطرناک و آنچه باید بدانید
-
مجموعه: بیماری ها و راه درمان

باکتریهای خطرناک میتوانند بیماریهای جدی ایجاد کنند
هشدار! این باکتریها سلامت شما را تهدید میکنند
اگرچه همه باکتریها مرگبار نیستند، برخی از آنها میتوانند به شدت به بدن آسیب برسانند و در صورت عدم تشخیص و درمان به موقع، بیماریهای مختلفی را ایجاد کنند. در ادامه، فهرستی از نه باکتری خطرناک برای انسان ارائه شده است که توسط سازمان بهداشت جهانی (WHO) منتشر شده و بیشترین تلفات انسانی را به دنبال داشتهاند.
شناخت این باکتریها، علائم و بیماریهای مرتبط با آنها برای حفظ سلامت خود و خانوادهتان اهمیت دارد. اکثر این باکتریها بیماریهای شایعی ایجاد میکنند که در صورت عدم درمان میتوانند زندگی را به خطر بیندازند. این فهرست همچنین نیاز به توسعه آنتیبیوتیکهای جدید توسط آزمایشگاههای پزشکی را برای مقابله مؤثر با این تهدیدات نشان میدهد.
تشخیص زودهنگام عفونتهای باکتریایی حیاتی است
باکتریهای خطرناک
1. آسینتوباکتر بومانی (Acinetobacter baumannii)
این باکتری شاید مقاومترین میکروارگانیسم امروزی باشد. سالانه هزاران نفر به دلیل عفونت ناشی از این باکتری جان خود را از دست میدهند، زیرا مکانیسمهای متعددی برای مقاومت در برابر داروهای درمانی دارد.
این باکتری آنزیمهایی تولید میکند که آنتیبیوتیکها را غیرفعال میکنند، پروتئینهای سطحی خود را تغییر میدهد تا از اثر داروها جلوگیری کند و پمپهایی برای دفع آنتیبیوتیکها از سیتوپلاسم خود دارد.
بیماریهای مرتبط:
• ذاتالریه شدید
• عفونت مجاری ادراری
• عفونت زخمها و آبسه در اندامهای مختلف
سطح خطر:
• اولویت بحرانی. آزمایشگاهها برای کشف داروهای جدید علیه این باکتری تحت فشار هستند.
2. پسودوموناس آئروژینوزا (Pseudomonas aeruginosa)
این باکتری حملات متنوعی دارد و گاهی تشخیص آن دشوار است. معمولاً بیماران با نقص ایمنی مانند مبتلایان به ایدز، فیبروز کیستیک، یا افرادی که در بیمارستان بستری هستند، در معرض خطر قرار دارند.
بیماریهای مرتبط:
• عفونت پوست، ریهها، مجاری ادراری، گوشها و دریچههای قلب
• عوارض ریوی و عفونتهای شدید در افراد مبتلا به ویروسهای دیگر
سطح خطر:
• بالا، بهویژه به دلیل ناتوانی بیماران با نقص ایمنی در مقابله با آن.

باکتریهای خطرناک گاهی بدون علائم در بدن زندگی میکنند
3. انتروباکتریاسه (Enterobacteriaceae)
این خانواده از باکتریها بیماریهایی را ایجاد میکنند که عمدتاً سیستم گوارشی و دفع (روده، معده و کولون) را تحت تأثیر قرار میدهند.
بیماریهای مرتبط:
• گاستروانتریت کودکان
• سالمونلا
• تب تیفوئید
• اسهال خونی
• عفونتهای شدید مجاری ادراری
این باکتریها در گذشته عامل مرگومیرهای زیادی در اپیدمیهایی مانند طاعون بودند و بسیاری از آنها به پنیسیلین مقاوماند.
جنبههای مهم:
• شامل بیش از ۶۰ جنس مختلف است که حدود ۲۵ جنس آن برای انسان از نظر بالینی اهمیت دارند، از جمله اشریشیا، سالمونلا، شیگلا، پروتئوس، کلبسیلا، سراتیا و انتروباکتر.
4. انتروکوکوس فاسیوم (Enterococcus faecium)
این باکتری میتواند بدون آسیب در روده انسان زندگی کند، اما در شرایط خاصی به عامل بیماریزا تبدیل میشود.
بیماریهای مرتبط:
• مننژیت نوزادی (با علائمی مانند سردرد، سفتی گردن، حساسیت به نور و تب)
• عفونتهای مجاری ادراری
• باکتریمی
• اندوکاردیت
• عفونتهای داخل شکمی، لگنی یا پوستی
سطح خطر:
• اولویت بالا اما نه بحرانی. این باکتری به برخی آنتیبیوتیکها مقاوم است و عامل نادر مننژیت نوزادی (۰.۳ تا ۴ درصد موارد) است.
5. استافیلوکوکوس اورئوس (Staphylococcus aureus)
این باکتری میتواند عفونتها و بیماریهایی در اندامهای مختلف بدن ایجاد کند.
بیماریهای مرتبط:
• سپسیس
• سلولیت
• مننژیت
• ذاتالریه
• التهاب ملتحمه
جنبههای مهم:
• حدود ۲۰ درصد از عفونتهای بیمارستانی، بهویژه در بخشهای مراقبت ویژه، به این باکتری نسبت داده میشود.
6. هلیکوباکتر پیلوری (Helicobacter pylori)
این باکتری بهطور انحصاری در معده زندگی میکند و معمولاً مخاط معده را آلوده کرده و باعث التهاب میشود.
بیماریهای مرتبط:
• گاستریت
• لنفوم
• زخمهای گوارشی
• تحریک کولون
برخی افراد بدون هیچ علامتی در تمام عمر خود به این باکتری آلوده میشوند. این باکتری از طریق بزاق، مدفوع و پلاک دندانی منتقل میشود.
سطح خطر:
به دلیل توانایی سازگاری با محیطهای خشن و مقاومت به آنتیبیوتیکهایی مانند آموکسیسیلین، مترونیدازول، کلاریترومایسین، فورازولیدون، لووفلوکساسین و تتراسایکلینها، بسیار خطرناک است.

چکاپ منظم به پیشگیری از بیماریهای باکتریایی کمک میکند
7. کمپیلوباکتر (Campylobacter)
این باکتری احتمالاً شایعترین عامل مسمومیت غذایی در سراسر جهان است.
علائم:
• تب
• اسهال
• استفراغ
• درد شکمی
بیماریهای مرتبط:
• آرتریت
• سندرم گیلن-باره
این باکتری از طریق مصرف غذاها یا آب آلوده و تماس با حیوانات ناقل منتقل میشود. اگرچه با آنتیبیوتیکهای معمولی قابل درمان است، اما به دلیل شیوع بالا، خطرناک محسوب میشود.
8. سالمونلا (Salmonella)
سالمونلا گروهی از باکتریهای متعلق به خانواده انتروباکتریاسه است.
بیماریهای مرتبط:
• عفونت سالمونلایی
• تب تیفوئید
• باکتریمی
• عفونتهای چرکی
علائم:
• تب
• استفراغ
• اسهال
• ناراحتی معده
دوره کمون این باکتری از یک هفته تا یک ماه متغیر است و علائم ممکن است تا دو ماه ادامه یابند. این باکتری میتواند برای مدت طولانی در محصولات لبنی مانند کره و شیر و همچنین در شکلات زنده بماند.
9. نایسریا گونورهآ (Neisseria gonorrhoeae)
این باکتری عامل بیماری گونوره، یک عفونت مقاربتی، است.
بیماریهای مرتبط:
• بیماری التهابی لگن در زنان (که میتواند به ناباروری منجر شود)
• عوارض بارداری مانند پارگی زودرس کیسه آب، زایمان زودرس، وزن کم نوزاد هنگام تولد و آلودگی نوزاد حین زایمان
جنبههای مهم:
• با آنتیبیوتیکهای ساده مانند آمپیسیلین و پنیسیلین قابل درمان است، اما خطر اصلی زمانی است که به موقع تشخیص داده نشود.
توصیههای مهم
• حداقل سالی یکبار چکاپ پزشکی انجام دهید تا از وضعیت سلامت خود آگاه شوید.
• عادات زندگی سالم را رعایت کنید و در صورت بروز علائم مداوم یا ناراحتی، فوراً به پزشک مراجعه کنید.
• از خوددرمانی پرهیز کنید، زیرا ممکن است باعث بروز عوارض شود. هرگونه مصرف دارو باید با مشورت پزشک باشد.
• تشخیص و درمان زودهنگام بیماریها، از جمله بیماریهای ناشی از این باکتریهای خطرناک، برای حفظ سلامت حیاتی است.

شستن دستها از انتقال باکتریهای خطرناک جلوگیری میکند
سوالات متداول درباره باکتریهای خطرناک برای انسان
1. باکتریهای خطرناک چیستند؟
باکتریهای خطرناک میکروارگانیسمهایی هستند که میتوانند بیماریهای جدی در انسان ایجاد کنند، بهویژه اگر به موقع تشخیص و درمان نشوند. مثالهایی شامل استافیلوکوکوس اورئوس، هلیکوباکتر پیلوری و سالمونلا هستند.
2. چگونه باکتریهای خطرناک منتقل میشوند؟
این باکتریها از طریق غذا یا آب آلوده، تماس با افراد یا حیوانات ناقل، رابطه جنسی، زخمهای باز، یا تجهیزات پزشکی آلوده منتقل میشوند.
3. علائم عفونتهای باکتریایی چیست؟
علائم بسته به نوع باکتری متفاوت است، اما شامل تب، اسهال، استفراغ، درد شکمی، التهاب، عفونت پوستی، یا مشکلات تنفسی میشود.
4. چرا برخی باکتریها به آنتیبیوتیک مقاوم هستند؟
استفاده نادرست یا بیش از حد آنتیبیوتیکها باعث میشود باکتریها مکانیسمهای مقاومتی مانند تولید آنزیمهای خنثیکننده یا تغییر ساختار سلولی ایجاد کنند.
5. آیا همه باکتریها مضر هستند؟
خیر، بسیاری از باکتریها بیضرر یا حتی مفیدند (مانند باکتریهای روده که به هضم غذا کمک میکنند). تنها برخی از آنها بیماریزا هستند.
6. چه کسانی بیشتر در معرض خطر عفونتهای باکتریایی هستند؟
افراد با سیستم ایمنی ضعیف (مانند بیماران مبتلا به ایدز، دیابت، یا سالمندان)، کودکان، و افرادی که در بیمارستان بستری هستند بیشتر در معرض خطرند.
7. آیا واکسن برای پیشگیری از عفونتهای باکتریایی وجود دارد؟
برای برخی باکتریها مانند مننژیت یا سیاهسرفه واکسن وجود دارد، اما برای بسیاری از باکتریهای خطرناک مانند استافیلوکوکوس اورئوس هنوز واکسن مؤثری تولید نشده است.
8. چگونه میتوان باکتریهای خطرناک را تشخیص داد؟
تشخیص معمولاً از طریق آزمایشهای میکروبیولوژیکی (کشت نمونه خون، ادرار، یا بافت) یا تستهای تشخیصی مانند PCR انجام میشود.
جمع بندی
باکتریهای خطرناک مانند آسینتوباکتر بومانی، استافیلوکوکوس اورئوس و هلیکوباکتر پیلوری تهدیدات جدی برای سلامت انسان هستند که میتوانند بیماریهای شدیدی مانند ذاتالریه، گاستریت و عفونتهای مقاربتی ایجاد کنند. در این مقاله از بیتوته به اهمیت تشخیص بهموقع، رعایت بهداشت و پرهیز از خوددرمانی برای پیشگیری و مقابله با این باکتریها تأکید شد. آگاهی از علائم و مراجعه سریع به پزشک میتواند جان انسانها را نجات دهد.
گردآوری:بخش سلامت بیتوته